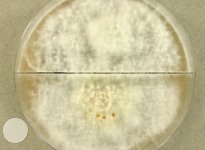
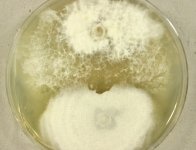
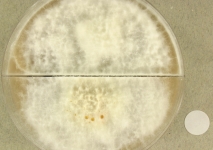

<< back to search
IMAGES:





_X7692 6wk window.jpg)



Search Details
add to cart
| UAMH Number: | 10914 |
|---|---|
| Species Name: | Schizophyllum commune |
| Type: | |
| Synonyms: | Agaricus alneus / Apus alneus / Daedalea commune / Merulius alneus / Merulius communis / Scaphophoeum agaricoides / Scaphophorum agaricoides / Schizonia vulgaris / Schizophyllum alneum / Schizophyllum alneus |
| Taxonomy: | FUNGI Basidiomycota, Agaricomycetes, Agaricales, Schizophyllaceae |
| Strain History: | Iwen, P. (UNMC S07-28039) -> UAMH |
| Substrate: | one of multiple positive cultures from sphenoid and ethmoid sinuses of male 23 yr, DE+ for hyphae with eosinophilic debris consistent with fungus ball | Location: | USA Nebraska, Omaha, University of Nebraska Medical Center (GEO: 41.255,-95.976) |
| Isolator: | |
| Isolation Date: | 2007 |
| Date Received: | 2008-05-28 |
| Characters: | BENOMYL tolerant @ 2 ppm - // CULTURE CONDITIONS cottony, somewhat degenerate - // CULTURE CONDITIONS no clamps or spicules in original isolate - // HUMAN/ ANIMAL PATHOGEN chronic rhinosinusitis - fide P. Iwen // ODOR/ ODOUR strong & unpleasant - (Click for publications citing UAMH 10914) |
| Compounds: | |
| Cross Reference: | UNMC S07-28039 |
| Collections: | Living Strains; Dried Herbarium Material |
| Pathogenic Potential: | Human: yes | Animal: no | Plant: yes |
| Biosafety Risk Group: | RG2 (check the PHAC ePATHogen Risk Group Database for updates) |
| Regulatory Requirements: | Canadian requesters must provide PHAC Pathogen and Toxin License Number (see: https://www.canada.ca/en/public-health/services/laboratory-biosafety-biosecurity/licensing-program.html) and a CFIA Written Authorization for transfer (http://www.inspection.gc.ca/plants/plant-pests-invasive-species/directives/date/d-12-03/eng/1432656209220/1432751554580#app2) prior to shipment. International requesters must provide all legally required importation documentation prior to shipment. This strain is not available for shipment to Cuba, the Democratic People's Republic of Korea, Iran or Syria. Plant pathogenicity status may be verified by using the USDA Agricultural Research Service (ARS) Fungal Database |
| MycoBank ID: | 208403 |
| Sequences: | >UAMH10914_FJ176397 CATTACGAATCAACAAGTTCATCTTGTTCTGATCCTGCACCTTATGTAGTCCTCTAAAGCCTTCACGGGCGGCGGTTGACTACGTCTACCTCACACCTTAAAGTATGTTAACGAATGTAATCATGGTCTTGACAGACCCTAAAAAGTTAATACAACTTTCGACAACGGATCTCTTGGCTCTCGCATCGATGAAGAACGCAGCGAAATGCGATAAGTAATGTGAATTGCAGAATTCAGTGAATCATCGAATCTTTGAACGCACCTTGCGCCCTTTGGTATTCCGAGGGGCATGCCTGTTTGAGTGTCATTAAATACCATCAACCCTCTTTTGACTTCGGTCTCGAGAGTGGCTTGGAAGTGGAGGTCTTGCTGGAGCCTAACCGAGCCAGCTCCTCTTAAATGCATTAGCGGATTTCCCTTGCGGGATCGCGTCTCCGATGTGATAATTTCTACGTCGTTGACCATCTCGGGGCTGACCTAGTCAGTTTCAATAGGAGTCTGCTTCTAACTGTCTCTTGACTGAGACTAGCGACTTGTGCGCTAACTTTGACTGACCTCAAATCAGGTAG |
IMAGES:

_X7692 6wk window.jpg)